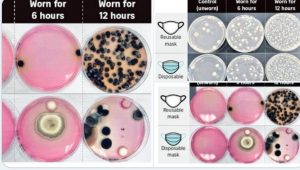

Masker menjadi benda yang wajib dipakai di masa pandemi Covid-19. Karena diyakini bisa mencegah penularan virus sampai 90 persen. Dengan catatan, penggunaannya tepat.
Sebaliknya. Alih-alih menecegah dari virus, jika digunakan tidak tepat, justru akan membahayakan pemakainya. Salah satu bentuk pemakaian masker yang tidak tepat adalah memakainya berulang kali. Sebab, hal ini bisa menjadikan masker mengandung bakteri dan mikroba yang berasal dari kulit dan droplet.
Dikutip dari laman detik health (20/5), sebuah percobaan yang dilakukan laboratorium Eurofins, Singapura, menunjukkan bahwa bakteri, ragi, dan jamur ditemukan dalam jumlah banyak ketika masker dipakai dalam waktu lama.
Eksperimen tersebut melibatkan masker sekali pakai dan masker yang dapat digunakan kembali, dipakai selama enam jam dan 12 jam untuk tujuan perbandingan.
Mereka kemudian diuji untuk melihat jumlah total bakteri, ragi dan jamur, serta Staphylococcus aureus, yang umumnya terkait dengan infeksi kulit, dan Pseudomonas aeruginosa, yang terkait dengan ruam.
Masker yang bisa dipakai lagi umumnya mengandung lebih banyak mikroba daripada yang sekali pakai.
“Mengingat kita dikelilingi oleh mikroba di lingkungan dan bahkan di dalam sistem pencernaan kita (mulut dan usus), tidak jarang ditemukan mikroba pada masker,” kata Profesor William Chen, direktur program Ilmu dan Teknologi Pangan Universitas Teknologi Nanyang, kepada Strait Times.
Sementara itu Dr John Common, peneliti utama di Skin Research Institute of Singapore, di Agency for Science, Technology and Research, mengatakan S. aureus dapat menghasilkan sejumlah racun yang terkadang merugikan manusia.
Penggunaan lebih dari 6 jam
Eksperimen tersebut menemukan masker yang dipakai dalam periode yang lama memiliki jumlah bakteri dan jamur lebih banyak sehingga meningkatkan risiko seseorang menjadi sakit.
Bakteri semacam itu, yang hidup di kulit yang sehat, dapat tumbuh hingga tingkat yang tinggi pada masker kotor dan menyebabkan penyakit.
“Pada tingkat rendah, sistem kekebalan Anda menjaga mereka tetap terkendali, tetapi pada tingkat yang tinggi, hal itu dapat menyebabkan reaksi alergi ringan hingga parah, masalah pernapasan, dan bahkan infeksi hidung,” kata Dr John Chen, asisten profesor di departemen mikrobiologi dan imunologi di National University of Singapore.
Karena sulit untuk memastikan apakah ada bakteri berbahaya yang ada pada masker, disarankan bagi orang untuk sering mencuci masker, atau menggantinya sesering mungkin.